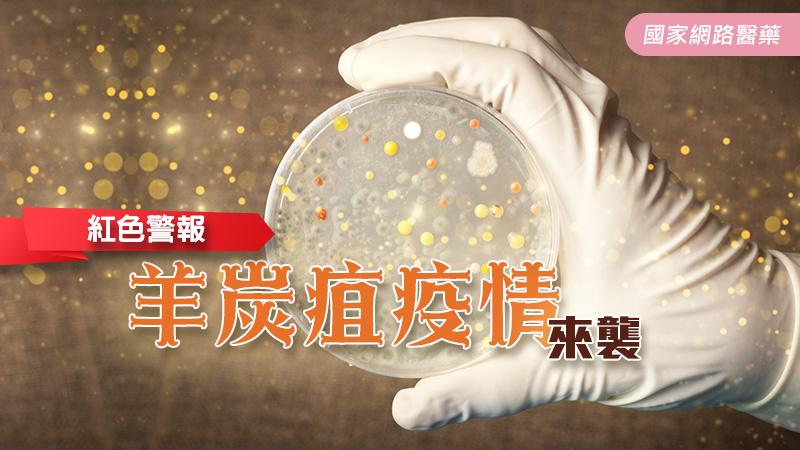
紅色警報－羊炭疽疫情來襲_圖1

當您註冊並成為KingNet國家網路醫藥網站(以下簡稱本網站)之會員時,表示您已經閱讀並願意遵守以下服務條款。往後任何新添加的功能也適用於以下條款,您可以在此看到最新版本的服務條款。
本網站得在不事先通知的情況下,保有隨時更新和更改本服務條款的權利。本網站建議您定時查閱最新的服務條款,並注意可能對您產生影響的更動。您於本服務條款之任何修改或變更後繼續使用本服務者,視為您已閱讀、瞭解並同意接受該等修改或變更。並且您同意不將本會員條款或任何本使用條款賦予您的權益或義務轉讓給他人。
若您不同意遵守此現有或未來修改後的服務條款,請勿繼續使用本網站之各項服務,並立刻停止參與一切有關本網站的各項活動。
第一、帳戶條款
1. 當您登入本網站進行會員註冊時,請務必提供您本人最新、正確及完整的資料,包含您的正式姓名、連絡電話、有效email,和任何本網站於您註冊時要求的各項資訊,以完成會員註冊。
2. 您的帳號及密碼由您自行保管,您必須確保帳號及密碼的機密性及安全性,本網站將不承擔您未確保帳號及密碼之機密性及安全性而產生的風險或損失。
3. 您不能使用本網站來從事非法或未經授權的行為。
4. 您必須對您在本網站帳戶下從事的所有行為和上傳內容(資料、圖表、照片、連結等)負責。
第二、法律義務與承諾
1. 您必須承諾絕不基於任何非法目的或以任何非法方式使用本網站開店、發表言論或提供資訊,並承諾遵守中華民國相關法規與一切使用網際網路之國際規範及慣例。
2. 您若係中華民國國民以外之使用者,您並同意遵守您所屬國家或地域之法令。您同意並保證不使用本網站從事任何侵害他人權益或違法行為,包括但不限於:
(1) 散播或發表任何具攻擊性、猥褻性、威脅性、毀謗性、不實、違反公共秩序或善良風俗或其他不法之文字、圖片或任何形式的檔案。
(2) 傳輸任何會侵犯他人權益的資料,包括但不限於隱私權、商業機密、商標權、專利權、著作權、智慧財產權及其他權利。
(3) 上載或散佈任何含有電腦病毒、木馬程式、惡意程式或任何意圖中斷、破壞、干擾或攔截電腦軟硬體功能之程式碼。
(4) 意圖隱瞞或偽造透過本網站傳送的資訊來源。
(5) 冒用他人名義或信用卡進行交易。
(6) 從事不法交易行為或張貼任何虛假不實或引人犯罪之訊息。
(7) 販賣毒品、槍枝、禁藥、偽藥、盜版品(軟體)或其他違禁品。
(8) 干擾或中斷本網站提供之各項服務或連接至此服務之伺服器或網路的行為。
(9) 濫發廣告郵件、垃圾郵件、連鎖信、違法之多層次傳銷訊息等。
(10) 傳送違反現行法律、國際相關法律的資料。
以上皆屬違法行為,一經發現本網站將會立即終止為您提供的服務,並立即提報相關單位協助處理,以保障其他合法使用者之權益。
第三、一般條款
1. 您透過本網站發表的各種言論(包括但不僅限於諮詢問題、就醫經驗、感謝信等),並不代表本網站贊同您的觀點或證實其內容的真實性。您在本網站上獲得的答覆、醫學文章、醫療保健資訊等,亦均不代表本網站贊同其觀點或證實內容的真實性,以上資訊不能作為您採取治療方案的直接依據,您應當聯繫醫生進行面對面的診療。
2. 本網站沒有義務對所有使用者的註冊資料、所有的活動行為以及與之有關的其它事項進行審查,本網站有權根據不同情況選擇保留或刪除相關資訊或繼續、停止對該使用者提供服務,並追究相關法律責任。在不須取得您事前同意的情況下,本網站擁有在任何時間、任何情形下更改或終止服務或拒絕提供服務的權利。
3. 您必須了解,您的資訊內容(信用卡資訊除外),會在未經加密的情形下傳遞至其他網路,或為配合技術需求而作更動。但信用卡資訊永遠會在加密情形下傳遞。
4. 本網站擁有移除任何非法、攻擊、威脅、中傷、誹謗、色情,或違反任何一方的智慧財產和服務條款帳戶的權利。
5. 除非經本網站書面同意允許,您不可以複製、販售、轉售本網站提供的任何一部分服務。
6. 因您於帳戶所為的任何行為或提供之資訊,而有任何口頭或書面對本網站、本網站其他會員、客戶、員工的不當指控、污辱或誹謗,本網站將有權立即終止您的帳戶。
7. 本網站並不擁有您所提供的任何素材的智慧財產權,任何您上傳的素材仍歸屬於您。您可以在任何時刻刪除相關素材,或直接刪除您的帳號且同時本網站也會移除您帳戶中所有內容。
8. 當您上傳圖片以及文字敘述到本網站時,即表示您同意任何人得瀏覽這些資料,也表示您同意本網站有權(全部或部分) 使用、複製、修改、發佈、翻譯和展示您公示於本網站上的各類資訊,或製作其派生作品,並使用於現在已知或日後開發的任何形式、媒體或技術上。
9. 本網站未行使某項權利時,不代表本網站放棄該項權利。
10. 您不可以使用本網站或本網站的商標來購買搜尋引擎關鍵字廣告或網域。
第四、第三方資源
1. 本網站或其他協力廠商可能會提供連結到第三方網站或網路資源的連結。僅為了增加使用者方便性,您可能會因此連結至其他業者經營的網站,但不表示本網站認可該網站的內容或與該網站有任何關係。
2. 本網站無法監視或控制由第三方提供之網路資源產生的結果。在使用這些網路資源時,請確保您對第三方的熟悉度,並同意第三方的使用條款。本網站建議您在使用這些網路資源前可以先諮詢專家建議。
3. 由第三方經營的網站均由各該第三方業者自行負責,不屬本網站控制及負責範圍之內,本網站對任何連結至本網站網頁上的第三方網址及其網站內容,並不保證其合適性、即時性、有效性及正確性。您也許會檢索或連結到一些令您感到排斥或不需要的網站,這是網際網路運作過程中可預見的結果,遇到此類情形時,本網站建議您不要繼續瀏覽或儘速離開該網站。您並同意本網站無須為您連結至非屬於本網站之其他網站所生之任何損害,負損害賠償之責任。
第五、智慧財產權保護政策
1. 本網站刊載之內容,包括但不限於文字報導、照片、影像、插圖、錄音檔案、影音檔案、網站畫面編排、網頁設計等素材,均受中華民國著作權法、國際著作權法律及智慧財產權等相關法律保障,其所享有之智慧財產權利包括但不限於商標權、專利權、著作權、營業秘密與專有技術等。
2. 本網站內容著作權係屬本網站或其他授權本網站使用之提供者所有。而本網站或相關連結網站所刊載內容或建置連結之網頁或資料,均由被連結網站所授權提供,本網站不擔保其正確性、即時性或完整性。您下載或拷貝本網站內容,或以任何形式將本網站內容傳輸、散布或提供予公眾者(包括但不限於轉貼連結、轉載內容等方式),皆不得基於商業目的或作為商業用途。此外,您利用本網站內容時須遵守著作權法的所有相關規定,不可變更、發行、播送、轉賣、重製、改作、散布、表演、展示以及利用本網站相關網站上局部或全部內容與服務賺取利益。
3. 倘您就本網站內容或相關連結網站之資訊作商業上使用時,應事先取得本網站的書面同意。
4. 本網站或相關連結網站所刊載內容之著作權聲明、商標或其他聲明,嚴禁任何更改或移除。
5. 本網站支持智慧財產權保護,也期望本網站及其協力廠商皆能遵守智慧財產權保護政策。若質疑本網站或本網站所連結之第三方網站內容侵犯他人智慧財產,可以透過[email protected]以E-mail方式聯繫客服人員,本網站會暫時停止您對部分內容做更動的權利。當您收到來自本網站通知您可能侵犯到他人智慧財產通知時,您同樣可以以E-mail方式申明您的立場並寄至前述電子郵件信箱。本網站會將您的回應傳達與權利人,並在確認您無侵犯智慧財產權之虞後14個工作天內,恢復您先前被凍結的權利。
第六、免責聲明
1. 本網站提供之線上諮詢服務可讓您進一步瞭解病情、病因,但無法提供醫療行為和取代醫師當面診斷,遇有疾病仍強烈建議您應立即至醫院診所就醫!
2. 本網站對提供之服務排除任何明示或暗示的聲明或擔保。其中包括但不限於適售性的擔保、特殊用途的擔保、權利完整的擔保,或對本網站的操作或內容資訊的正確性、準確性、完整性或準時性的擔保。但本網站仍將盡力維持網站上資料的正確性。
3. 本網站的一切內容均依其「現狀」提供。
4. 您了解任何網路資訊的傳送都有可能遭到攔截或盜用,因此本網站不能也無法保證本網站之網站本身、網站伺服器、或本網站與使用者間相關的電子郵件傳輸絕無病毒或有害程式。您必須自行承擔使用本網站可能產生的任何風險。
5. 本網站所提供之各項服務,有時可能會出現中斷或故障等現象,此或許將造成您使用上的不便,包括資料喪失、錯誤、遭人篡改或其他經濟上損失等情形。建議您於使用本服務時應自行採取防護措施。本網站不保證提供不間斷、即時、安全、無錯誤的網路服務。
6. 本網站不保證相關服務之絕對安全性及無瑕疵無失誤。如因本網站與相關網路系統及硬體設備之故障、失靈或人為操作上之疏失、駭客入侵等,而導致您無法傳輸、使用、或造成任何用戶資料內容(包括會員資料、文字、數字、圖片、聲音、影像)遺失、洩漏、缺漏、更新延誤或儲存上之錯誤,本網站均不負任何責任,您同意不向本網站請求賠償。
7. 本網站不保證服務提供的資訊結果完全準確可靠,亦不保證任何服務、資訊或產品(如有)的品質。
8. 本網站一概不承擔賠償因意外(包括感染電腦病毒、系統遭攻擊或突發任何漏洞)、誹謗、侵犯著作權或其他智慧產權所造成的損失,包括但不限於利潤、商譽、使用、資料損失或其他無形損失。本網站不承擔任何直接、間接、附帶、特別、衍生性或懲罰性之賠償責任。
9. 本網站有權因下列因素,包括但不限於系統修復、軟硬體更新、定期維護、網路品質不良或天災等人力不可抗拒之因素下,變更、暫時或永久停止繼續提供全部或部分服務。您同意本網站對您或任何第三方對於服務變更不負擔任何責任。
10. 使用本網站服務下載或取得任何資料時,您應自行考慮且自負風險,因前述任何資料之下載而導致用戶電腦系統之任何損壞或資料流失,本網站將不承擔任何法律責任。
第七、責任限制
您明確了解並同意無論在任何狀況下,本網站或其任何關係企業或個人及協力廠商,均無需為您任何因使用或無法使用本網站或內容所導致,或引發直接、間接、連帶、特殊、衍生、附隨、懲罰性的損害負責。其中包括但不限於失去業務、合約、收益、資料、資訊,或交易中斷或其他無形損失。即使本網站事先被告知該損害的可能性也同樣不承擔任何責任。
第八、補償
您同意補償本網站及一切相關人員,因您違反相關法令或本規範所致生之一切損害及責任。
第九、隱私權政策
對於您使用本網站各項服務時所留下的個人資料,本網站絕對予以尊重並且依據本網站的「隱私條款」加以規範保護。本網站絕不會把您寶貴的個人資料提供給任何與本網站無關的第三者。您可以點閱本網站的「隱私條款」以獲得更多資訊。
第十、爭議處理
本服務條款的任何條文在適當司法管轄權的法院被判定不合法、無效或因任何理由而無法執行,該無效條文不影響其餘條文的合法性及可執行性。本服務條款之解釋與適用,以及與本服務條款有關的爭議,均依照中華民國法律予以處理,並以台灣新北地方法院為第一審管轄法院。
第十一、其他事項
1. 本網站將努力提供您服務,並盡力對任何錯誤做更正。
2. 對服務條款有任何疑問,歡迎來信至[email protected]